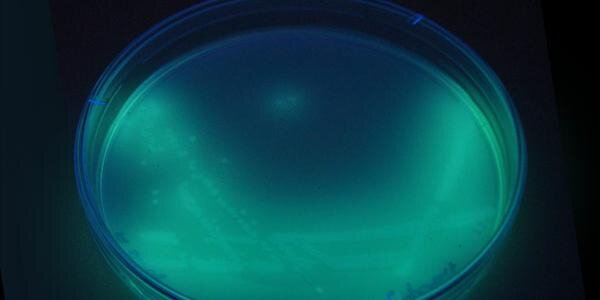
Freya Harrison banner

Freya Harrison
12.3K posts

Freya Harrison
@friendlymicrobe
Reader (Associate Prof) in #Microbiology @WarwickLifeSci #Biofilm, chronic #infection & @ancientbiotics Find me where skies are blue https://t.co/wFf8jHCJG4









A fantastic two days training colleagues old and new from 8 UK/Irish universities, @UKHSA and a CRO to set up our ex vivo model of biofilm infection in cystic fibrosis lungs, and discussing collaborative projects and proposals.



A fantastic two days training colleagues old and new from 8 UK/Irish universities, @UKHSA and a CRO to set up our ex vivo model of biofilm infection in cystic fibrosis lungs, and discussing collaborative projects and proposals.




We had an excellent day - superb teaching from @PhoebeMSilva & @LittleJ3nny, and excellent to see a big group of colleagues from academia & industry to talk lung #infection, #CysticFibrosis and #antimicrobial innovations.

We had an excellent day - superb teaching from @PhoebeMSilva & @LittleJ3nny, and excellent to see a big group of colleagues from academia & industry to talk lung #infection, #CysticFibrosis and #antimicrobial innovations.




Day 1 of our ex-vivo pig lung model workshop! 🐷 We’ve been dissecting both bronchiole and alveolar sections ✂️
